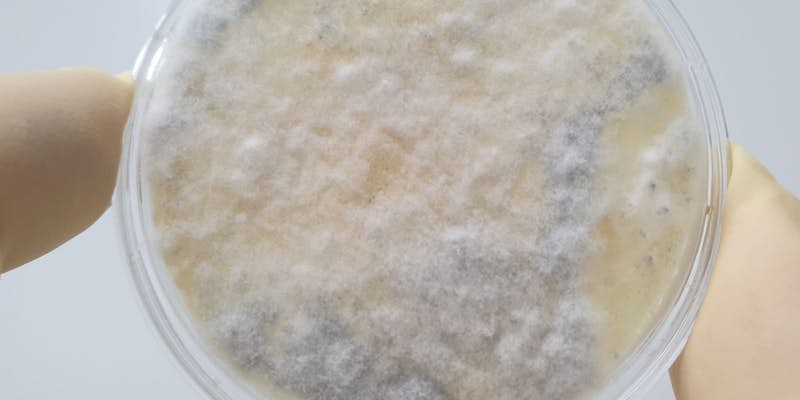

Mögel och röta i hus
Mögel och röta kan angripa hus och byggnader. Angreppen varierar i storlek och omfattning beroende på hur länge de pågått och hur fördelaktiga förutsättningarna är. Mögel, röta och andra mikroskopiska svampar och bakterier kallas ofta gemensamt för mikrobiell påväxt.
Relaterade artiklar
Här hittar du våra artiklar på ämnet. Hoppas du hittar något som intresserar dig. Trevlig läsning!